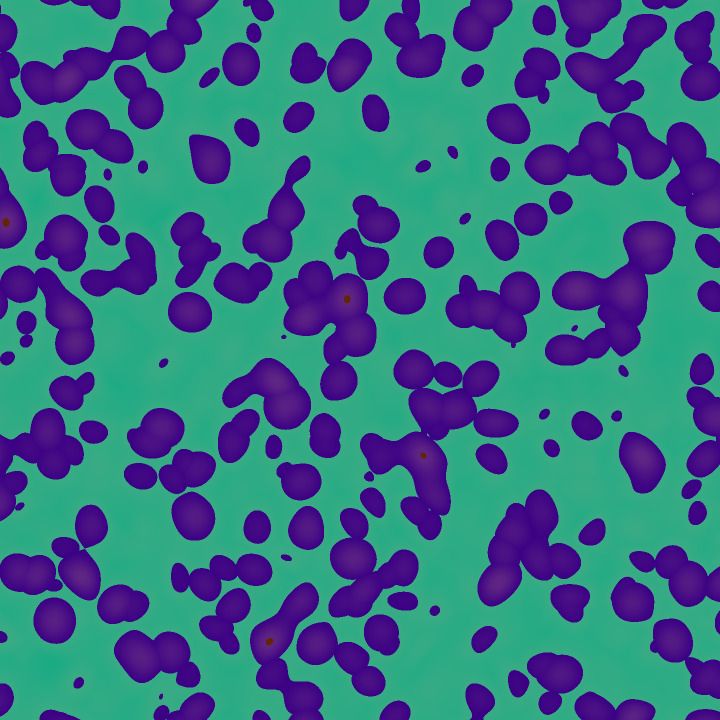

tweegeemee 트위지미
@tweegeemee.bsky.social
340 followers
360 following
38K posts
Bluesky variant of https://tweegeemee.com
Hourly evolutionary, generative art. Favorite & reblog/boost my images to select them for future generations.
Created by Roger Allen @rogerallen.bsky.social
Posts
Media
Videos
Starter Packs